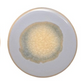
Stoneware Trivet with Reactive Glaze - Mellow Monkey

1
/
of
3
Stoneware Trivet with Reactive Glaze
Stoneware Trivet with Reactive Glaze
Regular price
$ 7.99
Regular price
Sale price
$ 7.99
Unit price
/
per
Couldn't load pickup availability
Shopify Secured Checkout
View full details
Product Features
- This stylish Round Stoneware Trivet with Reactive Glaze is a perfect addition to any kitchen!
- As each trivet is one of a kind, slight variations will occur.
- Sold separately.
- Measures 4-1/4-in